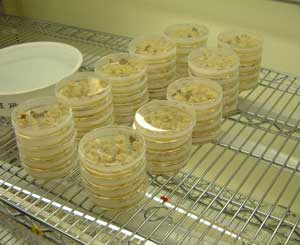

遺伝子組換え食品を考える - 準備
みんな夏休み明けてすぐの頃から、準備始めているのですよ。

10 月のある日の夜、東工大の某講義室にて

一応、マジメに会議中なんですよ・・・

遺伝子組換えの歴史担当の班の人たちです。

つくば市にある農水省施設に見学にも行きました。萱野先生、ありがとうございました。

隔離温室です。ここでは、水や空気の出入りが厳しく制限されています。

隔離温室は密閉されてるから、夏は蒸し風呂状態です。
それで、裏にはこんな大掛かりなエアコンがありました。

実験に使った物は、全てこの大きな殺菌装置で処理されます。
恒温室で、スクスク育つカルスたちです。この部屋は、「おいしそうな臭い」がしました。
きっと、おいしい培地を使っているのでしょうね。

